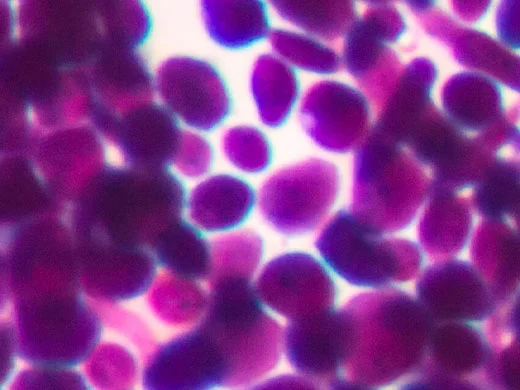

Palissandro
L'olio di palissandro ha proprietà rigeneranti che lo rendono ideale per ridurre rughe e imperfezioni.

Papaina
La papaina è un enzima naturale della frutta, eccellente per rimuovere le cellule morte della pelle. È particolarmente efficace nel ridurre le cicatrici da acne e le rughe sottili.

Papaya
Considerata un detergente per la pelle acneica, la papaya contiene l'enzima papaina che è in grado di dissolvere la cheratina.

Pappa reale
La pappa reale viene prodotta dalle api per nutrire l'ape regina. Contiene proteine, minerali, fattori di crescita e acqua, che la rendono un ingrediente rigenerante se applicata sulla pelle.

Papylactyl D
Questo ingrediente aiuta a rafforzare la struttura della pelle.

Patchouli
Il patchouli è un olio essenziale aromatico conosciuto per la sua azione rivitalizzante ed energizzante.

Pavonia
La Pavonia, o Padina pavonica, è un'alga mediterranea unica con eccezionali benefici antietà.

Peonia bianca
I meravigliosi fiori bianchi della peonia aiutano a lenire la pelle stanca e irritata.

Pepe rosa
Distillato a vapore dai grani di pepe rosa, quest'olio essenziale viene utilizzato per il suo aroma caldo e fruttato. Utilizzata storicamente per migliorare la circolazione, questa fragranza rivitalizzante è ideale per dare energia al corpo.
Peptide4
Formulato utilizzando tecniche avanzate di biologia molecolare, Peptide4 di ELEMIS è un peptide estratto dal lievito e ispirato ai ritmi circadiani per contribuire alla sincronizzazione dell'orologio interno della pelle.

Petitgrain
L'olio essenziale di petitgrain è estratto dai ramoscelli e dalle foglie dell'albero dell'arancio amaro, conosciuto per le sue proprietà terapeutiche e tonificanti.

Pino marittimo
Originario del Mediterraneo occidentale e sud-occidentale, il pino marittimo è ricco di antiossidanti e svolge un'azione efficace nel migliorare l'aspetto generale della pelle.

Pisello giallo
Il pisello giallo è una ricca fonte di aminoacidi essenziali, che favoriscono il metabolismo cutaneo per migliorare il processo di rigenerazione cellulare e l'idratazione.

Platano
Vari studi hanno dimostrato che il succo del platano, utilizzato sin dall'antichità da greci e romani, svolge un'azione antibatterica e antinfiammatoria.

Plumeria
Gli esotici fiori di plumeria regalano una sensazione di pace e armonia. Questa pianta deterge in profondità e promuove un aspetto giovane, donando un'idratazione profonda anche alle pelli più secche.

Poria cocos
Il Poria cocos è un fungo cinese indicato per supportare la microflora naturale della pelle, senza alterarne il pH. Crea un ambiente perfetto per la massima efficacia della terapia enzimatica e contiene un'elevata quantità di un complesso polisaccaridico che crea un film idratante compatibile con i livelli naturali di batteri della pelle. Contiene inoltre acidi e proteine organici per favorire la massima funzionalità cellulare.

Prezzemolo
Il prezzemolo è un componente di fragranza con rinomate proprietà antibatteriche.

Prolina
Questa miscela di aminoacidi derivati dalla canna da zucchero e dal mais aiuta a migliorare la funzione cellulare, attira l'umidità dell'atmosfera verso gli strati più profondi della pelle, difende la naturale funzione di barriera cutanea e promuove l'elasticità.

Propoli
La propoli è un vero e proprio cemento naturale fatto di resine di alberi e usato dalle api per proteggere l'alveare dalle infezioni.

Proteine del grano
Le proteine del grano migliorano l'idratazione e svolgono un'azione emolliente sulla pelle. Possono avere inoltre un effetto protettivo contro gli ingredienti aggressivi.

Proteine del latte
Le proteine del latte aiutano ad apportare alla pelle i nutrienti essenziali per migliorarne la salute.


